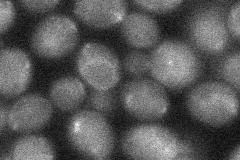
YGL257C
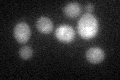
YGL257C

View description
Mannosyltransferase involved in adding the 4th and 5th mannose residues of O-linked glycans
Localization:
Intensity:
Fold change:
Significance:
-
C’ GFP library in SD

below threshold16.51 -
N' NOP1pr-GFP in SD

vacuole70.1553 -
N' TEF2pr-mCherry in SD

ER,vacuole143.385 -
N' NATIVEpr-GFP in SD

below threshold17.2079 -
N' TEF2pr-VC and Cyto-VN in SD
below threshold24.9518 -
C’ GFP library in SD+DTT
cytosol16.631No -
C’ GFP library in SD+H2O2

cytosol16.991.02No -
C’ GFP library in Starvation Media

cytosol15.090.91No -
C’ GFP library on the background of Pup2-DaMP

below threshold -
C’ GFP library on the background of CCT mutant

below threshold17.60811.06592No
